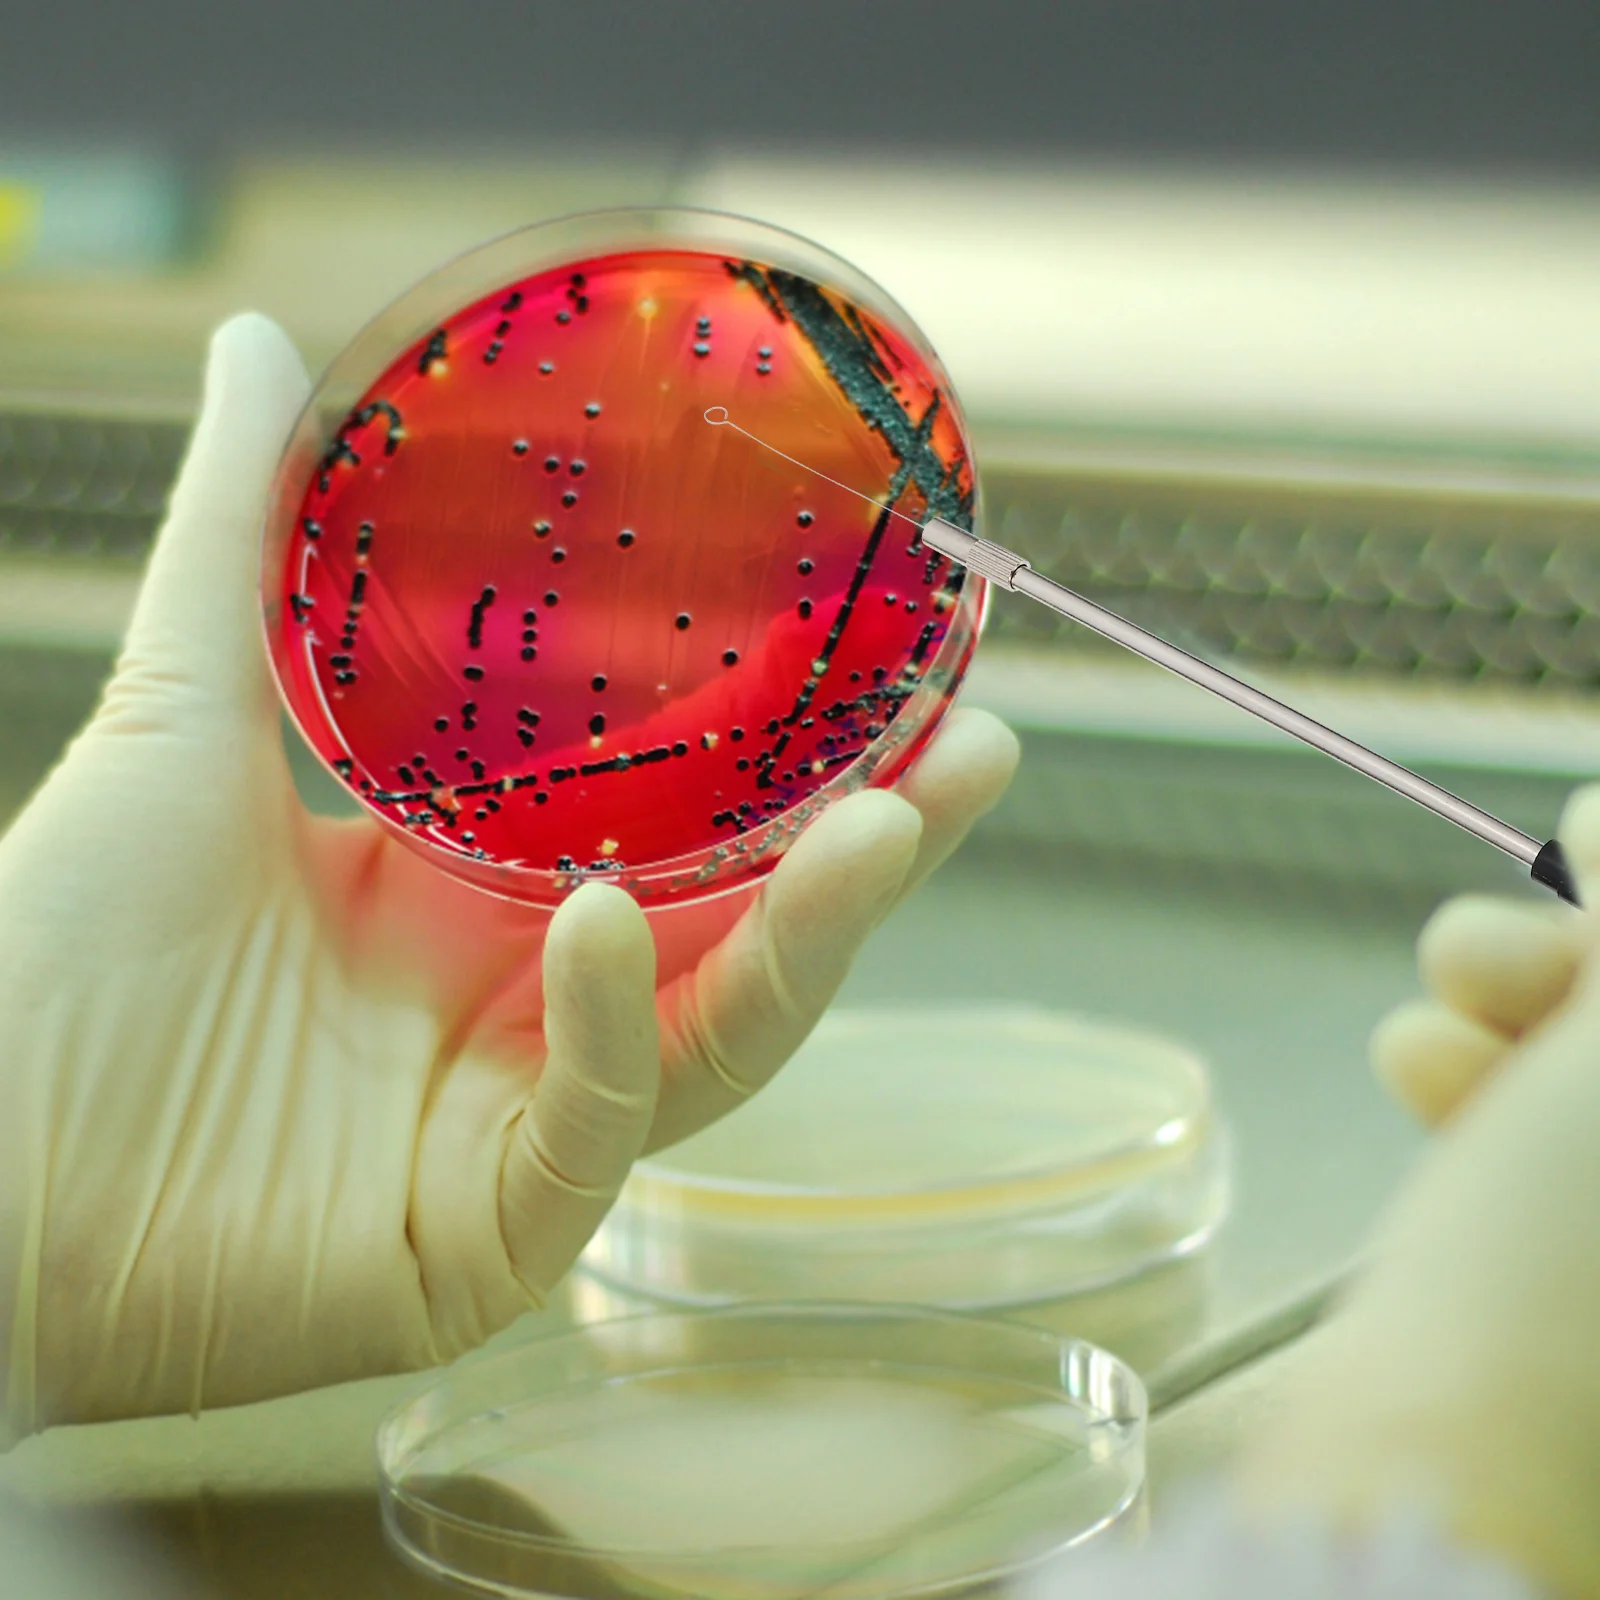

Лабораторная палочка для микробиологии
График изменения цены & курс обмена валют
Пользователи также просматривали

$4.73
Спортивная рубашка с принтом граффити для боулинга, рубашка на заказ для мужчин и женщин, рубашки азиатского размера с короткими рукавами и пуговицами, летний дышащий модный топ
aliexpress.ru
$1.99
Gaming Noise Cancelling Microphone Wired Headset Universal USB Gaming Headset for Call Center Office School PC Laptop
aliexpress.ru
$16.47
Автомобильная серебристая панель из нержавеющей стали для вентиляционной решетки кондиционера, отделка для Mercedes Benz X204 GLK 2008-12
aliexpress.ru
$5.88
Ruberthen 10 мм натуральный Lava энергии браслет из бисера для Для мужчин новый дизайн Для мужчин черный турмалинового браслета
aliexpress.ru
$2.59
Уважаемый покупатель, пожалуйста, не Загружайте фотографии в комментарии. В противном случае я должен удалить его. Спасибо (N013)
aliexpress.ru
$140.47
Передний спойлер для бампера из углеродного волокна 2XReal для BMW F80 M3 F82 F83 M4 Sedan Coupe Convertible 2014-2019
aliexpress.ru
$13.63
Uzui - The Sound Pillar T-Shirt Blouse sublime sweat big and tall t shirts for men
aliexpress.ru
$19.80
Auto Trim Removal Tool Kit 19Pcs Car Panel Door Window Tools Kit No-Scratch Auto Clip Pliers Fastener Remover Pry Tool
aliexpress.com
$17.47
Vintage Sweater Women Casual Chic Horn Button Thick Korean Cardigan Female Winter Warm Turndown Collar Loose Knitwears Lady
aliexpress.com
$9.30
1set Angle Grinder Gear Assembly For BOSCH TWS6600 GWS6-100 Replaceable Angle Grinder Power Tool Accessories
aliexpress.com
$19.08
Spring Autumn Trench Coat For Women Retro French Design Waist Navy Collar Small Temperament Long Sleeve Black Windbreaker Female
aliexpress.com
$6.71
Наволочка декоративная JoyArty "Нежность цветочного орнамента" на молнии, 45x45 см, Нежность цветочного орнамента
goods.ru
$64.65
Штангенциркуль GRIFF ШЦК-I-150-0,02 ГОСТ 166-89 (пр-во Guilin Measuring) D167003, ШЦК-I-150-0,02 ГОСТ 166-89 (пр-во Guilin Measuring) D167003
goods.ru
$110.97
Spina Optics 4-12X44 Tactical Riflescope Hunting Scope Mil Dot Illumination Reticle Sight Rifle Scope for Hunting Shooting
aliexpress.com
$0.84
Модная зимняя вязаная шапка бини с вышивкой Тесла теплые шапки регулируемые дышащие подарок для женщин мужчин детей
aliexpress.com
$149.99
Женское вечернее платье, светильник е платье в стиле Звезд, на Средний Восток, для дня рождения, 2021
aliexpress.com
$44.97
women's jackets hitom princess reflective women autumn 2021 streetwear long sleeve hooded short coat crop zipper bomber jacket, Black;brown
dhgate.com
$7.77
Новинка 2021, осенние платья в горошек для новорожденных девочек, платья принцессы с оборками, сетчатые Детские платья
aliexpress.ru
$4.32
Summer Kids Dresses for Girls Flower Frozen Elsa Print Princess Party Dress Girl Vestidos For Wedding Party Clothes Baby Costume
aliexpress.com
$20.41
Персонализированная трехмерная деревянная фотография в стиле Дня Святого Валентина
aliexpress.ru
$19.98
Non-Slip двойной кошка собачья миска с подставкой для кормления животных кота Переводные миска для кошек Еда миски для домашних животных для ко...
aliexpress.ru
$66.63
ANNYMOLI Chelsea Boots Women Shoes Real Leather Platform Mid Heel Short Boots Slip-On Thick Heels Lady Ankle Boots Autumn White
aliexpress.com
$22.10
2018 женская мода женская элегантный длинным рукавом кружева цветочные с плеча платье bodycon тонкий белый повседневная партия мини платье v, Black;gray
dhgate.com
$18.29
2020 straw pearl new parent-child straw japanese and korean wave edge hook pearl ribbon big hat summer sunscreen travel hat, Blue;gray
dhgate.com
$2.75
ice шелковой маски для лица с дыханием клапан моющегося маска многоразового anti-dust защитных масок черный корзины valve маски с пакетом gg, Blue;pink
dhgate.com
$22.96
20 autumn and winter men's homme color matching leather stitching mesh tie outdoor sports and leisure old shoes code 40-45
dhgate.com